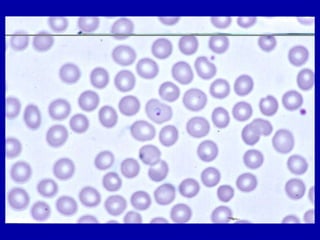
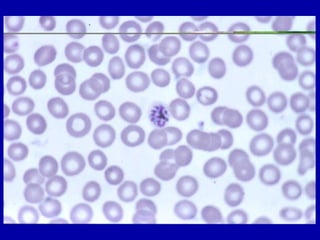
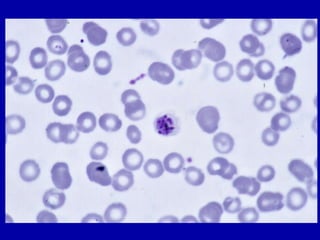
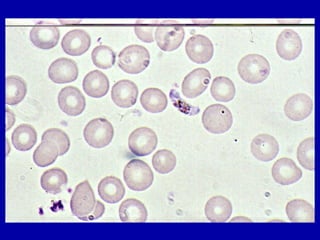
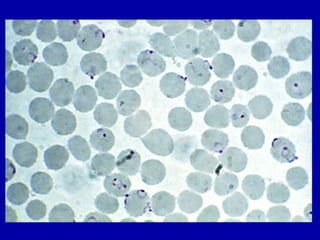

La malaria ha un impatto devastante, con 300-500 milioni di casi e oltre 2 milioni di morti all'anno, principalmente in Africa sub-sahariana. La resistenza ai farmaci sta aumentando, complicando ulteriormente il trattamento, e la malaria è recentemente riemersa in paesi dove era stata eradicata. Investimenti in ricerca e sviluppo per nuovi farmaci sono insufficienti, con solo il 10% delle risorse destinate a patologie che colpiscono il 90% della popolazione mondiale.




























![[ARDS in plasmodium vivax malaria] Perren A, Beretta F, Schubarth P. Servizio di Cure Intense, Ospedale San Giovanni, Bellinzona. Schweiz Med Wochenschr. 1198 Jun 20; Acute renal failure in Plasmodium vivax malaria. Prakash J, Singh AK, Kumar NS, Saxena RK. Department of Nephrology, Institute of Medical Sciences, Banaras Hindu University, Varanasi-221005. Assoc Physicians India. 2003 Mar;51:265-7.](https://image.slidesharecdn.com/seminariomalariavaleannalisa-111006162406-phpapp02/85/Malaria-29-320.jpg)